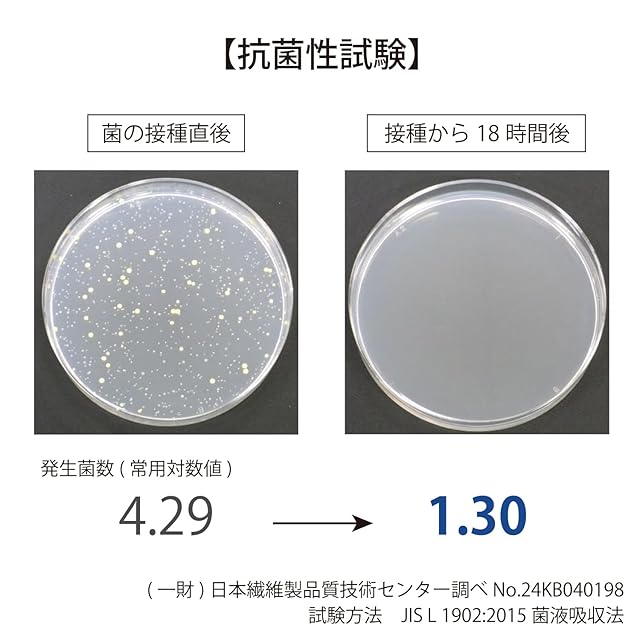

1/8
【WEB限定】ベーシック フェイスタオル 5枚セット グレー 抗菌 防臭 医師が考えた ハイドロ銀チタン 吸水 約34cm×80cm 61-5019250
¥3,514
International shipping available
【商品概要】
フェイスタオル:約34cm×80cm
ベーシック:軽さと柔らかさ、ほどよい厚みで普段使いに適したタオルです。
医師が考えた「ハイドロ銀チタン(Hyd[AgTiO2])」を使用した抗菌・防臭機能に優れたタオルです。
ニオイの元になる不衛生タンパク質を繊維上で分解しますので、部屋干しのイヤな生乾きのニオイを軽減します。
【商品詳細】
ブランド:ハイドロ銀チタン
商品種別:ホーム&キッチン
商品名:【WEB限定】ベーシック フェイスタオル 5枚セット グレー 抗菌 防臭 医師が考えた ハイドロ銀チタン 吸水 約34cm×80cm 61-5019250
製造元:タオル美術館
商品番号:61-5019250
商品内容:フェイスタオル5枚セット
色:グレー
商品タイプ:ベーシック
梱包サイズ:64.4cm
-
レビュー
(45)
最近チェックした商品
その他の商品